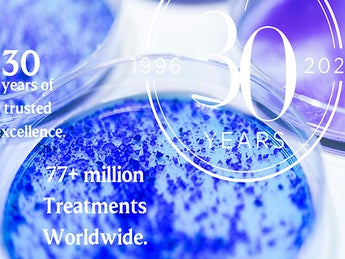
レスチレン30周年キャンペーン

Japan

2026.3.25 [重要なお知らせ]
【ご注意】ガルデルマ採用担当者を名乗るメールについて
ABOUT GALDERMA
Advancing Dermatology for every skin story
すべての人々の肌を美しく健やかに。
信頼され続けるプレミアムブランド
ガルデルマは1981年に創立しスイスに本社をおく、皮膚科学領域に特化した総合的スキンヘルスカンパニーとして世界最大級のグローバルな製薬会社です。
すべての人々の肌のニーズに応えるべく、美容医療、コンシューマーケア、医療用医薬品の3つのポートフォリオを提供、従業員数7,000名以上を擁し世界90カ国以上で展開しています。
日本法人のガルデルマ株式会社は、1996年に設立されました。現在はコンシューマー事業部、美容医療事業部の2つの事業部において、
セタフィル®(Cetaphil)、ヒアルロン酸注入材 などのブランドを有し、
すべての人々の肌を美しく健やかにするために信頼され続けるプレミアムブランドとして、様々なニーズに応じたビジネスを展開しています。
セタフィル®は75 年以上、世界70カ国以上で多くの方々に愛され続けている、敏感肌用スキンケアブランドです。
敏感肌や乾燥肌の多くの方々が、うるおいに満ちた健やかな肌を維持できるよう、様々な製品を生み出し、サポートし続けています。
ガルデルマの開発したヒアルロン酸使用軟組織注入材は、非動物由来安定化ヒアルロン酸フィラーとして、世界で最初にFDAで承認された製品です。
25年以上、6,500万回以上の施術実績と確立された安全性を誇り、世界中の人々の外見のみならず内面の健やかな美しさに貢献しています。
News from Galderma Japan
CAREERS
Advancing dermatology for every skin story
すべての人々の肌を美しく健やかに。
信頼され続けるプレミアムブランド
ガルデルマは、多様性を大切にするグローバル企業です。私たちはただ働くだけではなく、自分たちで考え行動します。
ガルデルマは、すべての従業員が急成長する環境の中で活躍できるようサポートします。自分の仕事にやる気や目標、情熱を持ち、自発的に新しいことに挑戦し、チェンジメーカーとなることを奨励しています。
日本はガルデルマの重要な拠点の一つです。当社のチームの一員としてさらなる事業の発展にあなたの実力を発揮してみませんか?
詳細はガルデルマのキャリアページをご覧ください。
LEGAL NOTICE UPDATE
当社は、この通知を変更および修正する権利を留保します。これらの情報や新しい追加情報を確認するには、このページを時々参照してください。
著作権 © 2023 Galderma S.A.
TRANSPARENCY GUIDELINES
ガルデルマは、透明性に関して適用される国の業界基準によって要求されるすべての情報を開示するために最善の努力を払うものとします。以下の医療機器事業活動に関連する医療従事者、医療機関、その他の組織に関する情報に関する文書は、ガルデルマ株式会社の透明性レポート方針を示しています。 ここでは、関連する透明性レポートをご覧いただけます。